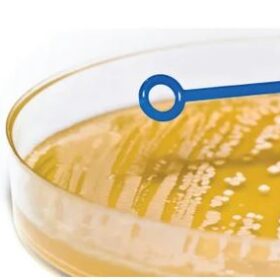

Description
∑-SP™ is a novel reagent in ready to use liquid format for the rapid liquefaction of sputum specimens in preparation for inoculation on automated platforms or by manual methods. The reagent has a more powerful mucolytic activity than dithiothreitol, but is also ready to use in a neutral pH solution that is stable at ambient temperature and requires no special storage conditions.
Features and Benefits:
- Recommended application: For rapid processing of sputum specimens. To use simply add 1ml of sputum directly to the ∑-SP™ vial, recap, vortex and allow to stand for about 15 minutes before processing. ∑-SP™ in ready to use format is particularly suited for use on automated platforms. The tubes and caps are completely compatible with most platforms currently in use.
- Neutral pH
- Powerful mucolytic
- Ready to use
- Ambient storage
- Effective recovery of respiratory bacteria
- Use directly with automated processing
- Convenient for manual processing
- Shelf life: 4 months
- Pack size: 50